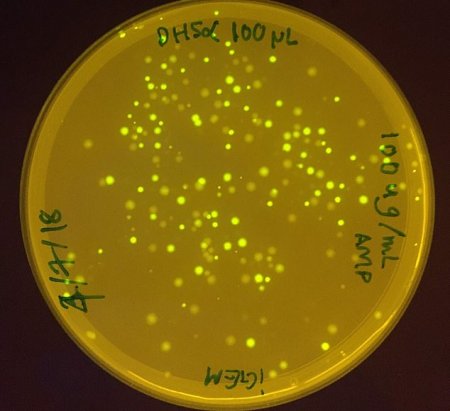

Генетически модифицированная бактерия сможет производить кислород на Марсе
Несмотря на то, что до начала первой миссии на Марс еще далеко, а о колонизации Красной планеты пока мы можем лишь мечтать, ученые уже разрабатывают различные варианты того, как обустроить четвертую планету от Солнца. Основной проблемой при колонизации Марса является отсутствие кислорода. Для
, , , , . . , . , .
. Daily Mail, , , . . , , , , 1% , .
,
, , , , . , ,
: ( ) . , . , . , , , .
.
Источник: "hi-news.ru"
Предыдущая статья
Мнения ученых относительно «инопланетного» происхождения Оумуамуа разделились
Следующая статья
Приложение EyeNav позволит управлять телевизором движениями глаз
Подпишитесь
И будьте в курсе первыми!
И будьте в курсе первыми!
Комментарии
Минимальная длина комментария - 50 знаков. комментарии модерируются